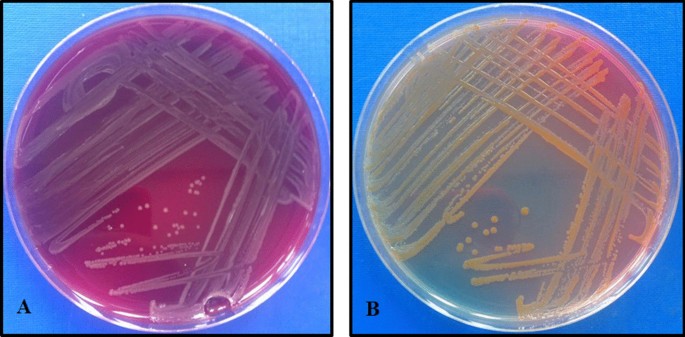

- Research
- Open access
- Published:
Occurrence of Pantoea agglomerans bloodstream infection in neonatal intensive care unit at tertiary hospital in Tanzania: antibiotic susceptibility profile and clinical outcome
Bulletin of the National Research Centre volume 48, Article number: 52 (2024)
Abstract
Background
Pantoea agglomerans (P. agglomerans) is an environmental gram-negative bacterium that rarely infects humans. P. agglomerans infections have never been reported in Tanzania. We investigated the occurrence of P. agglomerans bloodstream infections among neonates in the Intensive Care Unit (NICU) and their subsequent clinical outcome that occurred in 2019.
Methodology
Blood samples were collected from neonates with sepsis. A total of 19 P. agglomerans were isolated from 17 infected neonates; two of the neonates had P. agglomerans isolated twice. A total of 14 patient files were retrieved from medical records.
Results
The mean age of the infected neonates were 3.75 ± 7.95 days. Isolated P. agglomerans showed high sensitivity to the antibiotics particularly chloramphenicol (94.7%), piperacillin-tazobactam (94.7%) and meropenem (94.7%). The mortality rate was 71.4% with 35.7% of infected neonates dying before Antibiotic Susceptibility Test results for appropriate management. The Infection Prevention and Control (IPC) team shut the NICU for thorough decontamination which helped to stop the P. agglomerans occurrence.
Conclusions
P. agglomerans occurrence at the NICU was an uncommon aetiology pathogen for neonatal sepsis associated with high rates of mortality despite high sensitivity to multiple antibiotics. This calls for the strengthening of infection control measures and introduction of surveillance for environmental pathogens capable of causing human infections.
Background
Pantoea agglomerans is a gram-negative bacterium frequently isolated from environmental samples. The bacterium rarely causes human infections; in case of infection, P. agglomerans infects neonates and immunocompromised individuals (Büyükcam et al. 2018; Casale et al. 2023; Aljameely et al. 2024; Van Den Bosch et al. 2024). Neonatal sepsis of P. agglomerans presents similarly as other sepsis recorded in neonates including temperature liability, altered feeding behaviour, lethargy, jaundice, respiratory distress, and hypoglycaemia. Hospital-acquired P. agglomerans infection is associated with contaminated medical equipment such as intravenous catheters and contaminated intravenous fluids like anticoagulants, citrate dextrose solution, blood products and parenteral nutrition (Kaur et al. 2020; Van Den Bosch et al. 2024).
P. agglomerans outbreaks in neonates, paediatrics and cancer patients have been reported previously in Europe and North America (Kaur et al. 2020; Oo et al. 2021; Aljameely et al. 2024; Van Den Bosch et al. 2024). A study investigated a hospital-associated outbreak of P. agglomerans in an oncology clinic (Yablon et al. 2017). Twelve patient cases were identified due to poor preparation and handling of medications as a source of infection. Environmental samples revealed contamination in facility sinks, attributing the exposure of contaminated sinks. Concluding that improved medication preparation practices can control outbreaks (Yablon et al. 2017).
Due to the rare and opportunistic nature of P. agglomerans, resistance profiles of the bacteria have not been thoroughly evaluated. P. agglomerans isolated in a 12-year retrospective study in Hungary showed high levels of susceptibility to broad and narrow spectrum antibiotics (Gajdács 2019). The study in Hungary presented emerging of multi-drug resistance (MDR) stains of P. agglomerans with high resistance to amoxicillin-clavulanic acid (60%) and ampicillin (82.8%) similar to other gram-negative bacteria (Gajdács 2019).
Human infections with P. agglomerans have not been previously reported in Tanzania or Sub-Saharan Africa. Here, we report occurrence of P. agglomerans, clinical characteristics and outcomes of the patients in NICU at Muhimbili National Hospital (MNH).
Methods
Study design and setting
Our study took place between September and October of 2019. These data were retrieved and analysed for infected neonates admitted at the NICU with positive microbiological culture results that revealed P. agglomerans at Central Pathology Laboratory (CPL) at MNH. Patient files of positive blood culture samples were reviewed to collect relevant clinical data. MNH is the largest tertiary health care facility in Tanzania, with a 1500 bed capacity and serving as a university teaching hospital and a national referral hospital. Presently, the MNH attends to 1000–1200 outpatients per day with an estimated 1000–1200 admission per week. The MNH NICU on average admits about 10–20 neonates per day.
Study population
The population were neonates admitted at the NICU of MNH with a clinical diagnosis of neonatal sepsis categorised either as early onset neonatal sepsis (EONS) defined as signs of infection 0- to 72-h post-delivery or late onset neonatal sepsis (LONS) defined as signs of infection > 72-h post-delivery with a positive P. agglomerans blood culture sample.
Laboratory procedures
Anaerobic and aerobic blood samples were collected from NICU. Blood cultures were incubated in BD-BACTEC-FX40 until indication of presumptive presence of microorganism growth. Thereafter, primary gram-stain and inoculation of positive blood samples were performed on sheep blood agar base from HIMEDIA:M1301-500G, chocolate agar base HIMEDIA:M103-500G and MacConkey agar HIMEDIA:MHD81-500G incubated at 37 °C in ambient air for 18 to 24 h. Colony morphology, gram-stain and conventional biochemical tests were performed to identify the bacteria. Analytical Profile Index Test-20E (API-20E) was used to confirm the bacteria. Antibiotic susceptibility test (AST) for significant bacteria isolates were performed using Kirby-Bauer discs diffusion and categorized according to the Clinical and Laboratory Standards Institute (CLSI) (2019) antibiotic breakpoints for Enterobacterales.
Microbiological properties of P. agglomerans
Direct gram-stain from sample and culture revealed gram-negative bacilli. All isolated were wet, non-haemolytic colonies and produced yellow pigments on 5% sheep blood agar, while on MacConkey agar colonies were non-lactose fermenters with slight yellowish pigmentation. (Fig. 1). The isolates were found to be oxidase-negative, urease-negative, indole-negative, and non-motile and did not produce gas and H2S on Kligler’s iron agar. The conventional biochemical tests yield inconclusive results, and API-20E used identified the bacteria as P. agglomerans.
Ethical consideration
Ethical approval for the study was sought out from the Senate Research and Publications of Muhimbili University of Health and Allied Sciences (MUHAS): Reference Number: DA. 287/298/01A/. Waiver of informed consent was granted by Committee of MUHAS and permission to conduct the study at CPL was granted by the MNH administration: Reference Number: MNH/TRCU/IRB/permission/2019/117.
Results
Patients’ characteristics
A total of 19 P. agglomerans were isolated from 17 infected neonates as two infected neonates submitted samples to the laboratory twice. Out of the 17 neonates, only 14 patient files were retrieved. All the infected neonates affected by P. agglomerans BSI were pre-term: 78.6% of the neonates were delivered at MNH with the remaining referred to MNH for further treatment regarding prematurity and associated prematurity complications. The mean age of the patients were 3.75 ± 7.95 days old (IQR: 1 day to 19 days). The overall mortality was 71.4% as shown in Tables 1 and 2.
Antibiotic susceptibility profile of P. agglomerans, treatment and clinical outcome
The P. agglomerans isolates were highly sensitive to most of the tested antibiotics according to the CLSI 2019. Aztreonam (89.5%), chloramphenicol (94.7%), piperacillin-tazobactam (94.7%) and meropenem (94.7%) were the most effective drugs against P. agglomerans, while the lowest sensitivity was observed with ampicillin (68.4%), ciprofloxacin (68.4%), ceftazidime (68.4%), ceftriaxone (68.4%), cefepime (73.6%) and gentamycin (78.9%) as shown in Table 3.
Out of the 17 infected neonates, only 14 patient files of the infected neonates were retrieved. Table 1 illustrates that 64.3% (n = 9/14) of the cases received empirical antibiotics of which the P. agglomerans were susceptible to; however, 55.5% patients died despite appropriate initial antibiotics management. The duration of hospital stays for the patients with P. agglomerans infection was 16.2 days ± 3.75 days. A total of 28.6% of the infected neonates presented with MDR P. agglomerans infection, with one exhibiting carbapenem-resistant P. agglomerans.
Change of susceptibility pattern
We received two different samples from patients 12 and 16. AST was conducted on both samples submitted to the laboratory. Prior to the initiation of the initial antibiotic regimen showed that the isolates were sensitive to the antibiotics that have been tested. However, the AST results of blood samples collected five days after using the initial antibiotic regimen revealed that the isolates were resistant to the previously tested antibiotics particularly ampicillin, gentamycin, ciprofloxacin, ceftazidime and ceftriaxone.
Monthly trend of detection of P. agglomerans
The rise of P. agglomerans occurred in late September and October of 2019. The laboratory began noticing the abnormal trend of the isolated P. agglomerans in early October as the P. agglomerans isolation in the laboratory was uncommon and rare. The laboratory, therefore, notified the IPC team which decided to close the NICU for three days for thorough disinfection as other method of identifying the source of infection failed. After the ICU was reopened, active surveillance of P. agglomerans was continued for a period of four weeks without isolation of any P. agglomerans.
Discussion
The study aimed to describe the occurrence P. agglomerans transpired in the NICU at MNH between September and October 2019. P. agglomerans is a rare human pathogen, and as per our knowledge, this is the first time to be reported in hospital setting in Tanzania. The increase isolation of this pathogen was alarming as the bacteria is not among common aetiology isolated for BSI in NICU at MNH. The known common pathogen includes Klebsiella species, Escherichia coli, Coagulase-negative Staphylococci species, Staphylococcus aureus and Pseudomonas aeruginosa (Hani et al. 2023; Pishori et al. 2023; Andrea et al. 2023). Unfortunately, the source of the infection in this occurrence failed to be identified. Generally, there is limited information regarding the origin of P. agglomerans in the healthcare setting. However, studies suggest the spread of P. agglomerans is through ingestion of plant products, the presence of normal hand flora, and the household environment (Yablon et al. 2017; Hani et al. 2023; Van Den Bosch et al. 2024).
In the description of this occurrence, there is a significant time gap between the first isolated P. agglomerans BSI to the second isolated P. agglomerans as shown in Fig. 2. This suggests that the progression of the uncommon aetiology was through hospital-acquired infection (HAI) with the probable mode of transmission to be cross-infection and other contributing factors such as use of contaminated or poorly disinfected devices such as mechanical ventilators and catheters (Archibald and Jarvis 2011; Yablon et al. 2017; Wang et al. 2019; Masoud et al. 2022). In this study, most of the neonates were subjected to invasive procedures which also suggest that the spread of P. agglomerans infection may have been acquired at the hospital. There was several neonatal sepsis which were categorized as EONS as shown in Table 2. All the neonatal sepsis were suspected 48-h post-admission thus considered for reclassification to the HAI; however, still considered as EONS as occurred within 72 h post-delivery (Simonsen et al. 2014; Giannoni et al. 2018).
Out the 17 patients, two patients’ samples were submitted more than once to make a total sample received in the laboratory to be 19 and all were positive. The two blood samples were submitted approximately five days apart. One was at the initial diagnosis and another during the follow-up due to the deteriorating condition of the patient. Both the samples showed significant change of resistance pattern. The possible reasons to the change of resistance of the isolated bacteria could be a re-infection from other patients with different strains of the P. agglomerans or selection pressure after administration of the empirical antibiotics. A possible explanation for the bacterial acquisition of the resistance genes could also be exposure to antibiotic resistance genes (ARGs) in the NICU as Pantoea agglomerans is a common isolate in the environment (Mączyńska et al. 2023). A study examined the changes in development of resistance patterns among gram-negative Enterobacterales focusing particularly on Klebsiella pneumonia and Escherichia coli, over a period of five years from 2017 to 2021. Findings revealed effect of selection pressure reported on empirical broad-spectrum antibiotics used in guidelines according to the study setting (Mączyńska et al. 2023). Similarly, trends in the use of broad-spectrum antibiotics and its relationship to multidrug-resistant organisms (MROs) were analysed in a three-year surveillance research carried out in a tertiary care hospital in Kuala Lumpur, Malaysia. The results showed that the emergence of methicillin-resistant Staphylococcus aureus (MRSA), extended-spectrum beta-lactamase (ESBL)-producing Klebsiella spp., ESBL-producing Escherichia coli, and Acinetobacter baumannii was positively correlated with the consumption of fluoroquinolones and extended-spectrum cephalosporins (Tan et al. 2022). Several studies also report similar findings suggesting exogenous routes of acquired resistance of bacteria, including cross-infection, selection pressure or hospital-acquisition (Lynch et al. 2021; Abejew et al. 2024).
The mortality in this described occurrence was high in the P. agglomerans BSI infected neonates. Majority of the isolated showed in vitro sensitivity to the commonly used antibiotics in Tanzania as per the neonatal guideline. However, many infected neonates were premature, which increased their vulnerability to complications associated with prematurity and led to their deaths. Similarly reported in multiples case series describing Pantoea outbreaks in NICUs, all the neonates in the study were subjected to invasive procedures subsequently increasing their exposure to the P. agglomerans infection (Hani et al. 2023; Aljameely et al. 2024; Van Den Bosch et al. 2024).
Study limitation
The investigation failed to determine the source of P. agglomerans in the NICU. Initiating investigations to find the source of pathogen is necessary to prevent such occurrences in NICUs and other departments at MNH. No further isolation of P. agglomerans was identified post-fumigation and thorough disinfection of the NICU department for 3 days. The study also did not conduct any molecular characterization of the bacteria isolates which could have provided a useful insight on the development of MDR isolates.
The study did not include details of clinical information of patients which could further help to predict the source of the pathogen like invasive procedures which patient underwent such as parenteral nutrition, central venous access and surgical procedures. In addition, patient factors like gestational age, post menstrual age and mode of delivery were not included which could also play a role in patient outcome.
Conclusions
We demonstrated the presence of hospital-acquired P. agglomerans infections in the NICU at MNH. The findings showed that P. agglomerans BSI causes severe morbidity and mortality in the infected neonates. Further investigation is required to report the burden of HAI in NICU and other departments at MNH. The study suggests strengthening of the infection control measures in identifying pathogens, finding the source of origin, and surveillance for the environmental pathogens capable of causing human infections. The study further recommends thorough investigation of the underlying pathogenesis of P. agglomerans that have shown to cause high mortality in infected neonates.
Availability of data and materials
All data analysed during the current study are included in this published article.
Abbreviations
- BSI:
-
Bloodstream infection
- NICU:
-
Neonatal Intensive Care Unit
- MDR:
-
Multi-drug resistance
- MNH:
-
Muhimbili National Hospital
- CPL:
-
Central Pathology Laboratory
- EONS:
-
Early onset neonatal sepsis
- LONS:
-
Late onset neonatal sepsis
- AST:
-
Antibiotic susceptibility test
- CLSI:
-
Clinical and Laboratory Standards Institute
- MUHAS:
-
Muhimbili University of Health and Allied Sciences
- IPC:
-
Infection and prevention control
- HAI:
-
Hospital-acquired infection
- ARGs:
-
Antibiotic resistance genes
- ESBL:
-
Extended-spectrum β-lactamase Enterobacterales
References
Abejew AA, Wubetu GY, Fenta TG (2024) Relationship between antibiotic consumption and resistance: a systematic review. Can J Infect Dis Med Microbiol 2024:1–17. https://doi.org/10.1155/2024/9958678
Aljameely AA, Alzubaidi FM, Alsiny FI, Alzahrani FS, Hothan KA (2024) Pantoea species bacteremia in a child with sickle cell disease: a case report. Cureus. https://doi.org/10.7759/cureus.55122
Andrea C, Joachim A, Msafiri F, Mang’ombe E, Sangeda R, Manyahi J, Majigo M (2023) Laboratory-confirmed blood stream infections and antimicrobial resistance pattern of isolates from febrile pediatric patients at tertiary hospital in Tanzania. Tanzania J Health Res 24:149–162
Archibald LK, Jarvis WR (2011) Health care-associated infection outbreak investigations by the Centers for Disease Control and Prevention, 1946–2005. Am J Epidemiol. https://doi.org/10.1093/AJE/KWR310
Büyükcam A, Tuncer Ö, Gür D, Sancak B, Ceyhan M, Cengiz AB, Kara A (2018) Clinical and microbiological characteristics of Pantoea agglomerans infection in children. J Infect Public Health 11:304–309. https://doi.org/10.1016/J.JIPH.2017.07.020
Casale R, Boattini M, Bianco G, Comini S, Corcione S, Garazzino S, Silvestro E, De Rosa FG, Cavallo R, Costa C (2023) Bloodstream infections by Pantoea Species: clinical and microbiological findings from a retrospective study, Italy 2018–2023. Antibiotics 12:1723. https://doi.org/10.3390/ANTIBIOTICS12121723
Gajdács M (2019) Epidemiology and antibiotic resistance trends of Pantoea species in a tertiary-care teaching hospital: a 12-year retrospective study. Dev Health Sci 2:72–75. https://doi.org/10.1556/2066.2.2019.009
Giannoni E, Agyeman PKA, Stocker M, Posfay-Barbe KM, Heininger U, Spycher BD, Bernhard-Stirnemann S, Niederer-Loher A, Kahlert CR, Donas A, Leone A, Hasters P, Relly C, Riedel T, Kuehni C, Aebi C, Berger C, Schlapbach LJ (2018) Neonatal sepsis of early onset, and hospital-acquired and community-acquired late onset: a prospective population-based cohort study. J Pediatr 201:106-114.e4. https://doi.org/10.1016/J.JPEDS.2018.05.048
Hani S, Tahiri FE, Lalaoui A, Bennaoui F, Soraa N, El N, Slitine I, Mrabih F, Maoulainine R (2023) Pantoea SPP: a new nosocomial infection in the neonatal intensive care unit. Open J Pediatr 13:181–188. https://doi.org/10.4236/ojped.2023.132023
Kaur IP, Inkollu S, Prakash A, Gandhi H, Mughal MS, Du D (2020) Pantoea agglomerans bacteremia: is it dangerous? Case Rep Infect Dis 2020:1–4. https://doi.org/10.1155/2020/7890305
Lynch JP, Clark NM, Zhanel GG (2021) Escalating antimicrobial resistance among Enterobacteriaceae: focus on carbapenemases. Expert Opin Pharmacother 22:1455–1473. https://doi.org/10.1080/14656566.2021.1904891
Mączyńska B, Frej-Mądrzak M, Sarowska J, Woronowicz K, Choroszy-Król I, Jama-Kmiecik A (2023) Evolution of antibiotic resistance in Escherichia coli and Klebsiella pneumoniae clinical isolates in a multi-profile hospital over 5 years (2017–2021). J Clin Med 12:2414. https://doi.org/10.3390/JCM12062414
Masoud SS, Kovacevich A, Gangji R, Nyawale H, Nyange M, Ntukula A (2022) Extent and resistance patterns of ESKAPE pathogens isolated in pus swabs from hospitalized patients. Can J Infect Dis Med Microbiol. https://doi.org/10.1155/2022/3511306
Oo NAT, Edwards JK, Pyakurel P, Thekkur P, Maung TM, Aye NSS, Nwe HM (2021) Neonatal sepsis, antibiotic susceptibility pattern, and treatment outcomes among neonates treated in two tertiary care hospitals of Yangon, Myanmar from 2017 to 2019. Trop Med Infect Dis. https://doi.org/10.3390/TROPICALMED6020062/S1
Pishori T, Furia FF, Manji K (2023) A cross-sectional study of clinical features of bacterial meningitis among neonates presumed to have sepsis in a tertiary hospital, Dar es Salaam, Tanzania. Pan Afr Med J. https://doi.org/10.11604/pamj.2023.46.123.32787
Simonsen KA, Anderson-Berry AL, Delair SF, Dele Davies H (2014) Early-onset neonatal sepsis. Clin Microbiol Rev 27:21–47. https://doi.org/10.1128/CMR.00031-13
Tan SY, Khan RA, Khalid KE, Chong CW, Bakhtiar A (2022) Correlation between antibiotic consumption and the occurrence of multidrug-resistant organisms in a Malaysian tertiary hospital: a 3-year observational study. Sci Rep 12:1–9. https://doi.org/10.1038/s41598-022-07142-2
Van Den Bosch CH, Kops AL, Loeffen YGT, Van Der Steeg AFW, Van De Wetering MD, Fiocco MF, Ekkelenkamp MB, Wolfs TFW (2024) Central venous catheter-related bloodstream infections caused by Enterobacterales in pediatric oncology patients: catheter salvage or removal. Pediatr Infect Dis J 43:49–55. https://doi.org/10.1097/INF.0000000000004106
Wang L, Du KN, Zhao YL, Yu YJ, Sun L, Jiang HB (2019) Risk factors of nosocomial infection for infants in neonatal intensive care units: a systematic review and meta-analysis. Med Sci Monit 25:8213. https://doi.org/10.12659/MSM.917185
Yablon BR, Dantes R, Tsai V, Lim R, Moulton-Meissner H, Arduino M, Jensen B, Patel MT, Vernon MO, Grant-Greene Y, Christiansen D, Conover C, Kallen A, Guh AY (2017) Outbreak of Pantoea agglomerans bloodstream infections at an oncology clinic-Illinois, 2012–2013. Infect Control Hosp Epidemiol 38:314–319. https://doi.org/10.1017/ICE.2016.265
Acknowledgements
The authors would like to extend their sincere gratitude to the hardworking staff of the Central Pathology Laboratory, Neonatal Intensive Care Unit and Infection and Prevention Control team of Muhimbili National Hospital, Tanzania. The authors declare no funding was secured for this research.
Significance and impact of the study
To our knowledge, this is the first-time multiple cases of Pantoea agglomerans causing neonatal sepsis have been reported in the Sub-Saharan Africa. Affected neonates were followed up until outcome of interest: survive or death.
Funding
No funding was sought out for the current study.
Author information
Authors and Affiliations
Contributions
S.S.M. contributed to conceptualization, data curation, formal analysis, investigation, methodology, writing original draft and review and editing. M.M. contributed data curation, methodology, supervision, writing review and editing. R.R.G. contribute to conceptualization, data curation, formal analysis, investigation, methodology, writing original draft and review and editing. H.N. contributed to investigation, writing review and editing. A.N. and M.K. contributed to methodology and writing review and editing. F.M. and D.K. contributed to formal analysis and writing review and editing. J.M. contributed to formal analysis, writing review and editing and supervision. All authors have read and approved the manuscript.
Corresponding author
Ethics declarations
Competing interests
The authors declare that they have no competing interests.
Ethics approval and consent to participate
Ethical approval for the study was sought out from the Senate Research and Publications of Muhimbili University of Health and Allied Sciences (MUHAS): Reference Number: DA. 287/298/01A/. Waiver of informed consent was granted by Committee of MUHAS and permission to conduct the study at CPL was granted by the MNH administration: Reference Number: MNH/TRCU/IRB/permission/2019/117.
Consent for publication
Not applicable.
Additional information
Publisher's Note
Springer Nature remains neutral with regard to jurisdictional claims in published maps and institutional affiliations.
Rights and permissions
Open Access This article is licensed under a Creative Commons Attribution 4.0 International License, which permits use, sharing, adaptation, distribution and reproduction in any medium or format, as long as you give appropriate credit to the original author(s) and the source, provide a link to the Creative Commons licence, and indicate if changes were made. The images or other third party material in this article are included in the article's Creative Commons licence, unless indicated otherwise in a credit line to the material. If material is not included in the article's Creative Commons licence and your intended use is not permitted by statutory regulation or exceeds the permitted use, you will need to obtain permission directly from the copyright holder. To view a copy of this licence, visit http://creativecommons.org/licenses/by/4.0/.
About this article
Cite this article
Masoud, S.S., Majigo, M., Gangji, R.R. et al. Occurrence of Pantoea agglomerans bloodstream infection in neonatal intensive care unit at tertiary hospital in Tanzania: antibiotic susceptibility profile and clinical outcome. Bull Natl Res Cent 48, 52 (2024). https://doi.org/10.1186/s42269-024-01210-5
Received:
Accepted:
Published:
DOI: https://doi.org/10.1186/s42269-024-01210-5